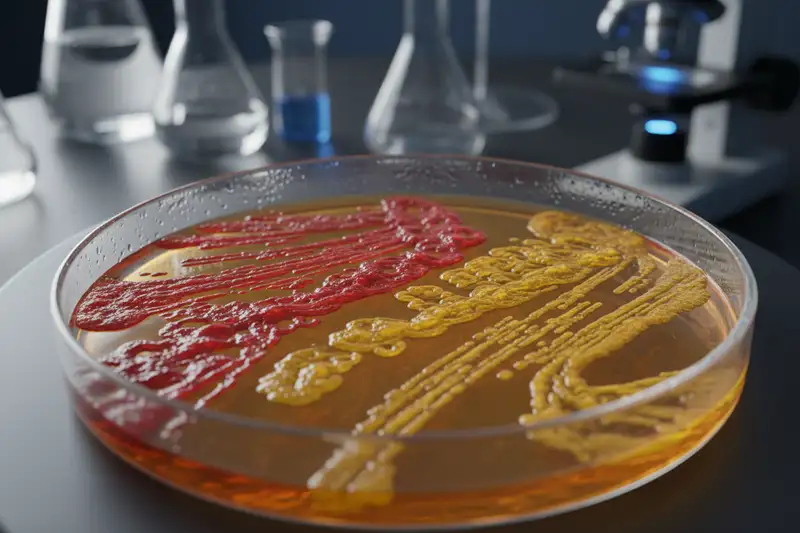
Mikrobiologische Untersuchungen liefern seit Jahren ein konsistentes Bild zugunsten von Papierhandtüchern

Händetrockner im Hygienecheck: Was die Forschung wirklich zeigt
Wer sich nach dem Toilettengang die Hände wäscht, hat den wichtigsten Schritt bereits getan. Doch was danach passiert, kann die gerade gewonnene Sauberkeit zunichtemachen. Elektrische Händetrockner gehören zur Standardausstattung öffentlicher Waschräume, von Flughäfen bis Einkaufszentren. Die Geräte versprechen Komfort und Nachhaltigkeit. Was sie nicht versprechen: dass die Hände danach tatsächlich hygienisch sauber sind. Seit mehr als einem Jahrzehnt liefern Mikrobiologen Belege dafür, dass insbesondere Jet-Trockner Keime nicht nur nicht entfernen, sondern aktiv in der Umgebung verteilen. Die Debatte darüber ist hitziger, als man es bei einem Alltagsgegenstand vermuten würde - nicht zuletzt, weil die Hersteller selbst kräftig mitforschen lassen.
Die Schlüsselstudien: Wie weit fliegen die Keime?
Den Auftakt der wissenschaftlichen Kontroverse markierte eine Studie der University of Westminster aus dem Jahr 2008. Die Forscher um Cunrui Huang verglichen drei Trocknungsmethoden: Warmlufttrockner, Jet-Trockner und Papierhandtücher. Das Ergebnis war eindeutig. Jet-Trockner schleuderten 60-mal mehr Keime in die Umgebungsluft als Warmlufttrockner und 1.300-mal mehr als Papierhandtücher. Die Studie wurde im Journal of Applied Microbiology veröffentlicht und gilt bis heute als Referenzarbeit.
2014 legten Forscher der University of Leeds nach. Das Team um Mark Wilcox, Professor für medizinische Mikrobiologie, untersuchte die Keimbelastung in Waschräumen eines Krankenhauses. In Räumen mit Jet-Trocknern fanden die Wissenschaftler signifikant mehr Bakterien in der Luft und auf Oberflächen als in solchen mit Papierhandtuchspendern. Die Keimzahl in der Luft war bis zu 4,5-mal höher. Besonders bemerkenswert: Die erhöhte Belastung ließ sich noch 15 Minuten nach dem letzten Trocknungsvorgang nachweisen.
Eine weitere Arbeit derselben Forschergruppe, publiziert 2016 im Journal of Hospital Infection, weitete den Blick auf drei Länder aus: Großbritannien, Frankreich und Italien. In allen drei Ländern bestätigte sich das Muster. Die Luft in Waschräumen mit Jet-Trocknern war stärker mit Bakterien belastet als in Räumen mit Papierhandtüchern. Die Studie wies zudem nach, dass sich darunter potenziell pathogene Keime befanden, darunter Staphylokokken und Enterobakterien.
2018 kam eine Untersuchung der University of Connecticut hinzu, die einen anderen Ansatz wählte. Die Forscher platzierten Petrischalen unter Händetrocknern in öffentlichen Waschräumen und dokumentierten das Bakterienwachstum. Das Ergebnis: Bis zu 254 Bakterienkolonien pro Schale nach nur 30 Sekunden Exposition. In der Kontrollgruppe, Petrischalen an der gleichen Stelle ohne laufenden Trockner, waren es lediglich sechs Kolonien.
Jet-Trockner, Warmluft, Papier: Der direkte Vergleich
Nicht alle elektrischen Händetrockner sind gleich problematisch. Die Unterscheidung zwischen den Gerätetypen ist wesentlich für die Bewertung.
Jet-Trockner (Hochgeschwindigkeitstrockner): Diese Geräte arbeiten mit Luftgeschwindigkeiten von bis zu 690 km/h. Sie pressen die Feuchtigkeit regelrecht von den Händen - mitsamt den darauf verbliebenen Mikroorganismen. Die hohe Luftgeschwindigkeit erzeugt Aerosole, die sich im gesamten Raum verteilen. Studien zeigen, dass die Keimbelastung in einem Radius von bis zu zwei Metern um das Gerät signifikant erhöht ist.
Warmlufttrockner: Die klassischen Geräte arbeiten mit deutlich geringerer Luftgeschwindigkeit. Sie verbreiten weniger Keime als Jet-Trockner, schneiden im Vergleich zu Papierhandtüchern aber ebenfalls schlechter ab. Ein zusätzliches Problem: Die Trocknungszeit beträgt 30 bis 45 Sekunden. Die meisten Nutzer brechen den Vorgang vorher ab und verlassen den Waschraum mit feuchten Händen. Feuchte Haut überträgt Bakterien bis zu 1.000-mal effizienter als trockene.
Papierhandtücher: In praktisch allen unabhängigen Studien schneiden Einmalhandtücher am besten ab. Der mechanische Reibungseffekt beim Abtrocknen entfernt zusätzliche Keime von der Hautoberfläche. Die Bakterien landen im Papier und damit im Abfall, nicht in der Raumluft. Zudem ist die Trocknungszeit deutlich kürzer, was die Compliance erhöht.
Aerosole und Viren: Die Debatte nach COVID-19
Die Corona-Pandemie hat die Diskussion um Händetrockner auf eine neue Ebene gehoben. SARS-CoV-2 verbreitete sich nachweislich über Aerosole - also genau jene feinen Tröpfchen, die Jet-Trockner in großer Menge produzieren.
Bereits 2020 rieten mehrere Fachgesellschaften dazu, in Zeiten erhöhter Infektionsgefahr auf Jet-Trockner zu verzichten. Die Logik dahinter: Selbst wenn das Händewaschen Viren von der Hautoberfläche entfernt, können sich in Jet-Trocknern Restfeuchtigkeit und Keime ansammeln. Bei jedem Trocknungsvorgang werden diese in die Umgebung abgegeben. Eine 2021 in der Fachzeitschrift "Indoor Air" publizierte Untersuchung bestätigte, dass Jet-Trockner die Aerosolkonzentration in geschlossenen Räumen messbar erhöhen.
Auch wenn SARS-CoV-2 primär über die Atemwege und nicht über die Hände übertragen wird, verdeutlichte die Pandemie ein grundsätzliches Problem: Geräte, die Aerosole produzieren, sind in Umgebungen mit hohem Personenaufkommen ein zusätzlicher Risikofaktor, insbesondere bei Erregern, die über die Luft übertragen werden. Dazu zählen neben Coronaviren auch Influenza, Noroviren und Tuberkulosebakterien.
Warum Krankenhäuser Jet-Trockner meiden
In Krankenhäusern, Arztpraxen und Pflegeeinrichtungen sucht man Jet-Trockner vergeblich - zumindest in solchen, die aktuelle Hygienerichtlinien ernst nehmen. Die Empfehlung der Kommission für Krankenhaushygiene und Infektionsprävention (KRINKO) beim Robert Koch-Institut ist unmissverständlich: In medizinischen Einrichtungen sollen Einmalhandtücher verwendet werden.
Die Begründung geht über die reine Keimverbreitung hinaus. In Krankenhäusern sind die potenziellen Konsequenzen einer Keimübertragung ungleich schwerwiegender als in einem Einkaufszentrum. Immungeschwächte Patienten, offene Wunden, multiresistente Erreger: Das Risiko, das von einer erhöhten Keimbelastung in der Raumluft ausgeht, wiegt hier besonders schwer.
Die Weltgesundheitsorganisation (WHO) empfiehlt in ihren Leitlinien zur Händehygiene ebenfalls Einmalhandtücher als bevorzugte Trocknungsmethode im medizinischen Bereich. In der 2009 veröffentlichten Richtlinie "WHO Guidelines on Hand Hygiene in Health Care" heißt es explizit, dass Händetrockner für klinische Bereiche nicht empfohlen werden.
Auch außerhalb des medizinischen Sektors gibt es Einrichtungen, die reagiert haben. Einzelne Schulen und Universitäten haben Jet-Trockner nach Beschwerden über Lärm und Hygiene durch Papierhandtuchspender ersetzt. In der Gastronomie schreiben die Lebensmittelhygieneverordnungen mehrerer Bundesländer Einmalhandtücher für Mitarbeiter in der Küche vor.
Industrie gegen Wissenschaft: Wem kann man trauen?
Die Debatte um Händetrockner wird dadurch kompliziert, dass ein erheblicher Teil der verfügbaren Studien von der Industrie finanziert wurde - auf beiden Seiten.
Dyson, Hersteller des weit verbreiteten Airblade, hat mehrfach eigene Studien in Auftrag gegeben, die seinen Geräten Unbedenklichkeit attestieren. Eine 2019 veröffentlichte Untersuchung im Auftrag von Dyson kam zu dem Schluss, dass Jet-Trockner nicht mehr Bakterien verbreiten als andere Trocknungsmethoden, sofern die Hände zuvor gründlich gewaschen wurden. Das Unternehmen betonte zudem, dass der Airblade über einen HEPA-Filter verfüge, der 99,97 Prozent der Partikel aus der angesaugten Luft entferne.
Auf der anderen Seite finanziert die European Tissue Symposium (ETS), eine Interessenvertretung der Papierhandtuchindustrie, seit Jahren Forschung, die die Überlegenheit von Papierhandtüchern belegen soll. Die bereits genannte Studie von Mark Wilcox aus Leeds wurde teilweise von der ETS unterstützt.
Für die Bewertung der Studienlage ist diese Transparenz entscheidend. Die unabhängige Forschung, also Studien ohne direkte Industriefinanzierung, tendiert mehrheitlich zu dem Ergebnis, dass Jet-Trockner die Keimverbreitung in Waschräumen erhöhen. Doch auch hier gibt es methodische Unterschiede. Manche Studien arbeiteten mit künstlich kontaminierten Händen, die deutlich mehr Keime trugen als Hände nach einer normalen Wäsche. Andere untersuchten die Keimbelastung unter Realbedingungen, mit naturgemäß geringeren Unterschieden.
Ein Meta-Review aus dem Jahr 2022, veröffentlicht in "Infection Control & Hospital Epidemiology", wertete 23 Studien aus und kam zu einem differenzierten Ergebnis: Unter kontrollierten Laborbedingungen verbreiten Jet-Trockner nachweislich mehr Mikroorganismen als Papierhandtücher. Unter Alltagsbedingungen ist der Unterschied geringer, aber weiterhin vorhanden.
Die Umweltfrage: Papier gegen Strom
Das stärkste Argument der Händetrockner-Industrie ist ökologischer Natur. Papierhandtücher verursachen Abfall: pro Person und Trocknungsvorgang etwa zwei bis drei Tücher, bei geschätzt mehreren Milliarden Nutzungen jährlich allein in Deutschland eine erhebliche Menge. Hinzu kommen Herstellung, Transport und Entsorgung.

Elektrische Händetrockner benötigen Strom, verursachen aber keinen direkten Abfall. Lebenszyklusanalysen kommen je nach zugrunde gelegten Annahmen zu unterschiedlichen Ergebnissen. Eine häufig zitierte Studie des MIT aus dem Jahr 2011 kam zu dem Schluss, dass Händetrockner über ihre gesamte Lebensdauer einen geringeren CO2-Fußabdruck haben als Papierhandtücher, vorausgesetzt, der Strom stammt nicht ausschließlich aus fossilen Quellen.
Allerdings sind diese Berechnungen komplex und von zahlreichen Variablen abhängig: Stromquelle, Auslastung des Geräts, Art des Papiers (Recycling oder Frischfaser), Transportwege, Entsorgungsmethode. Eine pauschale Aussage ist daher schwierig. Was sich sagen lässt: Beide Methoden haben einen ökologischen Fußabdruck, und keine ist eindeutig "grün".
Neuere Ansätze versuchen, den Konflikt zwischen Hygiene und Nachhaltigkeit zu entschärfen. Papierhandtücher aus 100 Prozent Recyclingfasern, sparsame Spendersysteme und die kompostierbare Entsorgung verringern den ökologischen Nachteil der Papierlösung. Auf der anderen Seite arbeiten Hersteller an leiseren, energieeffizienteren Trocknern mit besserer Filtration.
Was das RKI und die WHO empfehlen
Die offiziellen Empfehlungen sind bemerkenswert klar, zumindest für den medizinischen Bereich.
Das Robert Koch-Institut empfiehlt in seinen Richtlinien zur Händehygiene Einmalhandtücher als Standardmethode in medizinischen Einrichtungen. Warmlufttrockner werden als akzeptable Alternative genannt, Jet-Trockner hingegen nicht empfohlen.
Die WHO-Richtlinie von 2009 formuliert es ähnlich: Einmalhandtücher sind die bevorzugte Methode. Die Organisation weist ausdrücklich darauf hin, dass die Art der Trocknung die Keimzahl auf den Händen beeinflusst und dass unzureichende Trocknung die Übertragung von Mikroorganismen begünstigt.
Für den öffentlichen Raum außerhalb medizinischer Einrichtungen gibt es keine verbindlichen Vorschriften zur Trocknungsmethode. Hier bleibt die Entscheidung dem Betreiber überlassen, der in der Regel nach Kosten und Praktikabilität urteilt.
Worauf es wirklich ankommt: richtiges Händewaschen
Bei aller berechtigten Diskussion über die Trocknungsmethode gerät ein entscheidender Punkt leicht aus dem Blick: Die mit Abstand wichtigste Maßnahme zur Handhygiene ist das Waschen selbst. Und hier hapert es gewaltig.
Beobachtungsstudien zeigen regelmäßig, dass ein erschreckend hoher Anteil der Bevölkerung die Hände entweder gar nicht, nur mit Wasser oder viel zu kurz wäscht. Eine Studie der Michigan State University ergab, dass nur fünf Prozent der beobachteten Personen ihre Hände mindestens 20 Sekunden lang mit Seife wuschen, wie es die Empfehlung vorsieht. Eine Erhebung der Bundeszentrale für gesundheitliche Aufklärung (BZgA) kam für Deutschland zu etwas besseren, aber immer noch ernüchternden Ergebnissen.
Die korrekte Technik nach WHO-Empfehlung umfasst sechs Schritte: Handflächen gegeneinander reiben, rechte Handfläche über linken Handrücken (und umgekehrt), Finger ineinander verschränken, Außenseite der Finger auf gegenüberliegender Handfläche, Daumen einzeln reinigen und Fingerspitzen in der gegenüberliegenden Handfläche kreisen lassen. Der gesamte Vorgang sollte mindestens 20 Sekunden dauern.
Wer diese Schritte gewissenhaft befolgt, hat den allergrößten Teil der Keime bereits entfernt - unabhängig von der anschließenden Trocknungsmethode. Die Trocknungsfrage ist also relevant, aber sie ist zweitrangig gegenüber der Waschqualität.
Fazit: Pragmatismus statt Panik
Wer die Wahl hat, sollte zu Papierhandtüchern greifen. Das ist das klare Ergebnis der unabhängigen Forschung, und es ist die Empfehlung der maßgeblichen Gesundheitsinstitutionen. Wer nur einen Jet-Trockner vorfindet, muss deswegen nicht in Panik verfallen: Das Risiko einer Infektion durch einen einzelnen Trocknungsvorgang ist gering.
Entscheidend ist die Reihenfolge der Prioritäten. An erster Stelle steht gründliches Händewaschen mit Seife, mindestens 20 Sekunden, alle Bereiche der Hände einbeziehen. An zweiter Stelle steht vollständiges Trocknen, denn feuchte Hände sind die eigentliche Keimschleuder. Und erst an dritter Stelle steht die Frage, womit man trocknet.
Für Betreiber öffentlicher Einrichtungen ergibt sich daraus eine Abwägung. In sensiblen Bereichen - Krankenhäusern, Pflegeheimen, Kindergärten, Gastronomiebetrieben - sprechen die Fakten klar für Papierhandtücher. In weniger kritischen Umgebungen kann die Entscheidung zugunsten von Händetrocknern fallen, sofern die Geräte regelmäßig gewartet und gereinigt werden.
Was bleibt, ist die unbequeme Wahrheit, dass die beste Trocknungstechnologie nichts nützt, wenn die Hände vorher nicht richtig gewaschen wurden. Die größte Hygienebaustelle befindet sich nicht an der Wand neben dem Waschbecken, sondern davor.





